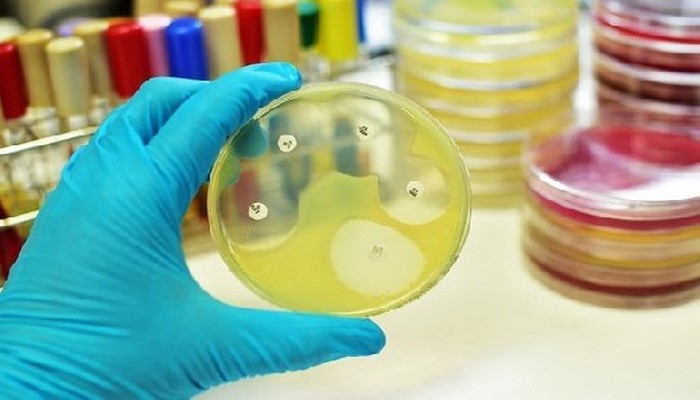

Создан антибиотик, побеждающий все бактерии
Ученые из Принстонского университета в США обнаружили соединение, которое побеждает самые устойчивые к антибиотикам бактерии. Результаты исследования были опубликованы в журнале Cell.
Kак сообщает Ens.az со ссылкой на Med2.ru
Соединение SCH-79797, обладающее двойным действием, может одновременно прокалывать стенки бактерий и разрушать фолиевую кислоту в их клетках. При этом у бактерий не вырабатывается к нему лекарственной устойчивости.
Отметим, за последние тридцать лет не появилось ни одного нового препарата, способного убивать грамотрицательные бактери, которые, в отличие от грамположительных, защищены внешним слоем, оберегающим их от большинства антибиотиков.
Как подчеркнул профессор Земером Гитай, SCH-79797 одновременно атакует изнутри и снаружи, и может уничтожить даже самых сильных противников ? от кишечной палочки Escherichia coli до стафилококка и гонококка, устойчивых ко всем известным антибиотикам.
"Это первый антибиотик, который без сопротивления воздействует и на грамположительные и на грамотрицательные бактерии. Мы надеемся, что в будущем это приведет к появлению новых типов антибиотиков", ? завил Гитай.
Он указал, что соединение назвали "иррезистин".
Основная проблема антибиотиков заключается в том, что бактерии быстро вырабатывают к ним резистентность, однако исследования показали, что ни один патоген не может противостоять SCH-79797.
Так, ученые в течение 25 дней снова и снова подвергали патогены воздействию препарата, и даже получили из хранилищ Всемирной организации здравоохранения наиболее устойчивый штамм гонококка Neisseria gonorrhoeae, который входит в топ-5 самых сложных для лечения.
И во всех случаях иррезистин показал высокую эффективность.










Комментарии
Показать комментарии Скрыть комментарии